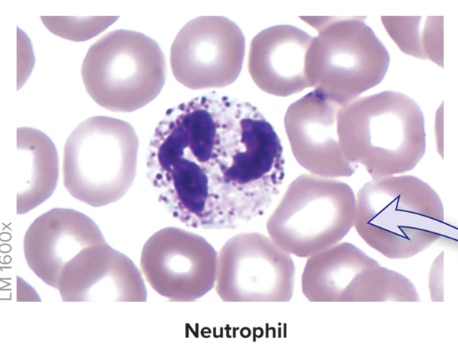
<p><strong>Most numerous</strong> <strong>leukocyte </strong>in blood,&nbsp;<strong>50-70%</strong> of all white blood cells</p><ul><li><p><strong>Multilobed </strong>nucleus</p></li><li><p>Cytoplasm has<strong> pale granules</strong> when stained</p></li></ul><ul><li><p>Enter tissue spaces and<strong> phagocytize infectious pathogens</strong></p></li><li><p><strong>Numbers rise</strong> dramatically in chronic <strong>bacterial infection</strong></p></li></ul><p></p>
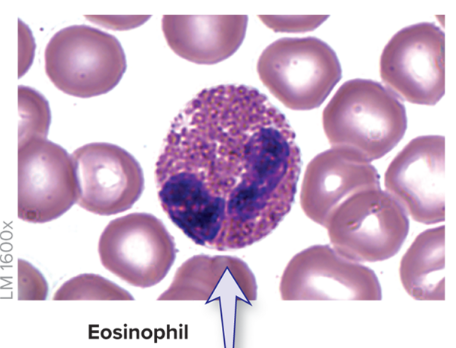
<p><strong>less common</strong>, <strong>1–4% </strong>of leukocytes</p><ul><li><p><strong>Bilobed nucleus</strong> connected by thin strand</p></li><li><p>Cytoplasm has<strong> reddish granules</strong></p></li><li><p><strong>Phagocytize </strong>antigen-antibody complexes or <strong>allergens</strong></p></li><li><p><strong>Active </strong>in cases of <strong>parasitic worm infection</strong></p></li></ul><p></p>
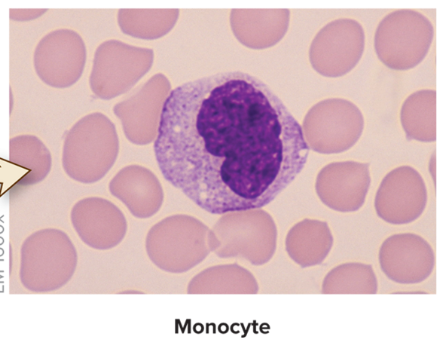
<p><strong>2–8%</strong> of blood leukocytes</p><ul><li><p><strong>C-shaped </strong>nucleus</p></li><li><p>Take up<strong> residence in tissues</strong></p></li><li><p><strong>Transform </strong>into large phagocytic cells, <strong>macrophages</strong></p></li><li><p><strong>Phagocytize bacteria, viruses, debris</strong></p></li></ul><p></p>
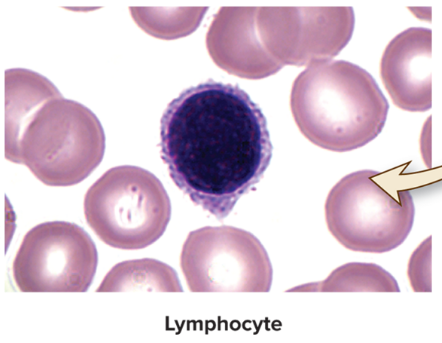
<p><strong>20–40%</strong> of blood leukocytes</p><ul><li><p>Reside in<strong> lymphoid organs and structures</strong></p></li><li><p><strong>Dark-staining</strong> round nucleus </p></li><li><p><strong>Three categories:</strong></p></li></ul><ol><li><p><strong>T-lymphocytes</strong> manage <strong>immune response</strong></p></li><li><p><strong>B-lymphocytes</strong> become <strong>plasma cells</strong> and produce <strong>antibodies</strong></p></li><li><p><strong>NK (natural killer) cells</strong> <strong>attack abnormal </strong>and <strong>infected </strong>tissue cells</p></li></ol><p></p>
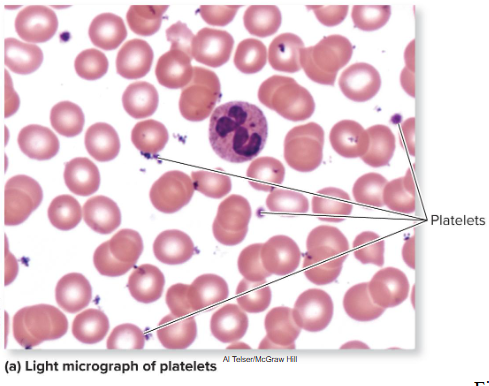
<p>Small, membrane-enclosed cell fragments </p><ul><li><p><strong>No nucleus</strong></p></li><li><p><strong>Break off of megakaryocytes</strong> in red marrow</p></li><li><p>Important role in <strong>blood clotting</strong></p></li><li><p>Normally <strong>150,000 to 400,000</strong> per cubic millimeter blood</p></li><li><p><strong>30%</strong> stored in <strong>spleen</strong></p></li><li><p>Circulate for <strong>8 to 10 days</strong>; then <strong>broken down and recycled</strong></p></li></ul><p></p>

1/38
Looks like no tags are added yet.
Name | Mastery | Learn | Test | Matching | Spaced |
|---|
No study sessions yet.
formed elements make up __% of blood
45
erythrocytes
fxn: transport oxygen and carbon dioxide
life span: 120 days
avg density: 4.8-5.4 mil
leukocytes
fxn: initiate immune response
life span: 12 hours (neutrophils) to years (hymphocytes)
avg density: 4500-11,000
platelets
fxn: hemostasis
life span: 8-10 days
avg density: 150,000-400,000
hematopoiesis
production of formed elements
begins in embryonic period, fifth week of development in liver
5 months when hemato. begins in red bone marrow
hemocytoblasts (stem cells)
stem cells
multipotent: can differentiate into many types of cells
goes into either
myeloid line
lymphoid line
myeloid line
forms erythrocytes, all leukocytes except lymphocytes, and megakaryocytes (cells that produce platelets)
lymphoid line
forms only lymphocytes
Colony-stimulating factors (CSFs)
stimulate hematopoiesis
Erythropoiesis
erythrocyte production, make up 99% of our formed elements
Process requires iron, B vitamins, amino acids, and EPO
Begins with myeloid stem cell—responds to multi-CSF
Forms progenitor cell
Forms proerythroblast—a large nucleated cell
Becomes erythroblast—smaller, produces hemoglobin
Becomes normoblast—still smaller, more hemoglobin, anucleate
Becomes reticulocyte—lacks organelles except ribosomes that make hemoglobin
Becomes erythrocyte—ribosomes have degenerated
Leukopoiesis
production of leukocytes, less than 1% of formed elements
Involves maturation of granulocytes, monocytes, lymphocytes
Granulocytes are neutrophils, basophils, and eosinophils
Multi-CSF and GM-CSF cause myeloid stem cell to form progenitor cell
Progenitor cell becomes myeloblast that becomes a granulocyte
Monocytes also derived from myeloid stem cells
Stem cell differentiates into progenitor cell
M-CSF prompts progenitor cell to become a monoblast
Monoblast becomes a promonocyte, which matures into a monocyte
Leukopoiesis (continued)
Lymphocytes are derived from lymphoid stem cells
Stem cells differentiate into B-lymphoblasts and T-lymphoblasts
Lymphoblasts mature into B-lymphocytes and T-lymphocytes
Some lymphoid stem cells differentiate directly into NK (natural killer) cells
Thrombopoiesis
platelet production
Megakaryoblast produced from myeloid stem cell
Forms megakaryocyte under influence of thrombopoietin
Large size and multilobed nucleus
Megakaryocyte produces thousands of platelets
produces proplatelets—long extensions
extend through blood vessel wall into bloodstream
Blood flow “slices” off fragments which are platelets
Erythrocytes
red blood cells
Lack nucleus and cellular organelles; packed with hemoglobin
Have biconcave disc structure
Has latticework of spectrin protein providing support and flexibility
Transport oxygen and carbon dioxide between tissues and lungs

Hemoglobin
red-pigmented protein, Transports oxygen and carbon dioxide
oxygenated when maximally loaded with oxygen
deoxygenated when some oxygen lost
Each hemoglobin molecule is composed of four globins
Two alpha chains and two beta chains
Each chain has a heme group: a porphyrin ring with an iron ion in its center
Oxygen binds to the iron ion, so each hemoglobin can bind four oxygen molecules
4 iron = 4 oxygen
Carbon dioxide binds to globin protein (not iron)
erythropoiesis (EPO) steps
controlled thru negative feedback, Erythropoietin (EPO)
stimulus - decrease in blood oxygen
receptors - chemoreceptors in kidney
control center - cells in kidney release EPO
effector - Red marrow myeloid cells respond to EPO by making more erythrocytes
net effect - The erythrocytes increase blood’s oxygen carrying capacity
negative feedback - Increase in blood oxygen inhibits EPO release (negative feedback)

EPO other stimuli
Testosterone stimulates EPO production in kidney
males have higher erythrocyte count, higher hematocrit
Environmental factors (like altitude) influence EPO levels
Low oxygen levels at high altitude stimulate EPO
Erythrocyte destruction
Lacking organelles, erythrocytes cannot synthesize proteins for repairs
Maximum life span is 120 days
Globin and membrane proteins are broken into amino acids
Used by body for protein synthesis
hemoglobin breakdown steps
liver and spleen
globin broken down into free amino acids
heme converted into green pigment biliverdin
then into (unconjugated) bilirubin
blood
unconjugated bilirubin binds with albumin and transported to liver
liver
unconjugated bilirubin removed from blood by liver and converted into conjugated bilirubin
liver
bilirubin then eliminated from liver into small intestine
small intestine
bilirubin converted into urobilinogen
then two fates:
small and large intestine (80%)
urobilinogen > stercobilin > feces
blood and kidneys (20%)
urobilinogen absorbed back into blood into urobilin, yellow pigment excreted by kidneys
transferrin
transports iron form hemoglobin to liver
Bound to storage proteins: ferritin, hemosiderin
Most is bound to ferritin and stored in liver and spleen
Transported to red bone marrow as needed for erythrocyte production
ABO antigens
Type A blood: erythrocytes have surface antigen A only
Type B blood: erythrocytes have surface antigen B only
Type AB blood: erythrocytes have both antigens
Type O blood: erythrocytes have neither antigen

ABO antibodies
Type A blood has anti-B antibodies in its plasma
Type B blood has anti-A antibodies in its plasma
Type AB blood has neither anti-A nor anti-B antibodies in its plasma
Type O blood has both anti-A and anti-B antibodies in its plasma

Rh blood types
Presence or absence of Rh factor (surface antigen D) determines if blood type is positive or negative
present = Rh positive
absent = Rh negative

ABO donation

agglutination
someone receives an incompatible transfusion
Recipient’s antibodies bind to transfused erythrocytes and clump them together
Can block blood vessels, prevent normal circulation, can cause hemolysis, rupture of erythrocytes, organ damage

agglutination test
type A blood clumps due to anti-A antibodies from type B blood

leukocyte cheat sheet

Leukocyte characteristics
Defend against pathogens
Contain nucleus and organelles, but not hemoglobin
Motile and flexible—most not in blood but in tissues
Diapedesis: process of squeezing through blood vessel wall
Chemotaxis: attraction of leukocytes to chemicals at an infection site
Five leukocyte types divided into two classes
leukocyte classes
Granulocytes have visible granules seen with light microscope
Neutrophils, eosinophils, basophils
Agranulocytes have smaller granules that are not visible with light microscope
Lymphocytes, monocytes
granulocytes: neutrophils
Most numerous leukocyte in blood, 50-70% of all white blood cells
Multilobed nucleus
Cytoplasm has pale granules when stained
Enter tissue spaces and phagocytize infectious pathogens
Numbers rise dramatically in chronic bacterial infection
granulocytes: eosinophils
less common, 1–4% of leukocytes
Bilobed nucleus connected by thin strand
Cytoplasm has reddish granules
Phagocytize antigen-antibody complexes or allergens
Active in cases of parasitic worm infection
granulocytes: basophils
rare, 0.5–1% of leukocytes
Bilobed nucleus
Cytoplasm has blue-violet granules with histamine and heparin
Histamine release causes increase in blood vessel diameter (vasodilation) and capillary permeability (classic allergy symptoms)
Heparin release inhibits blood clotting (anticoagulation)

agranulocytes: monocytes
2–8% of blood leukocytes
C-shaped nucleus
Take up residence in tissues
Transform into large phagocytic cells, macrophages
Phagocytize bacteria, viruses, debris
agranulocytes: lymphocytes
20–40% of blood leukocytes
Reside in lymphoid organs and structures
Dark-staining round nucleus
Three categories:
T-lymphocytes manage immune response
B-lymphocytes become plasma cells and produce antibodies
NK (natural killer) cells attack abnormal and infected tissue cells
differential count
measures amount of each type of leukocyte and whether any are immature
Neutropenia
decreased neutrophil count
May occur with anemia, drug or radiation therapies
eosinophilia
Eosinophil numbers rise during allergic reactions, parasitic infections, and some autoimmune diseases
Lymphocytosis
increase in lymphocytes
Caused by viral infections (for example, mumps, mononucleosis)
Also caused by chronic bacterial infections, some leukemias, and multiple myeloma
Platelets
Small, membrane-enclosed cell fragments
No nucleus
Break off of megakaryocytes in red marrow
Important role in blood clotting
Normally 150,000 to 400,000 per cubic millimeter blood
30% stored in spleen
Circulate for 8 to 10 days; then broken down and recycled